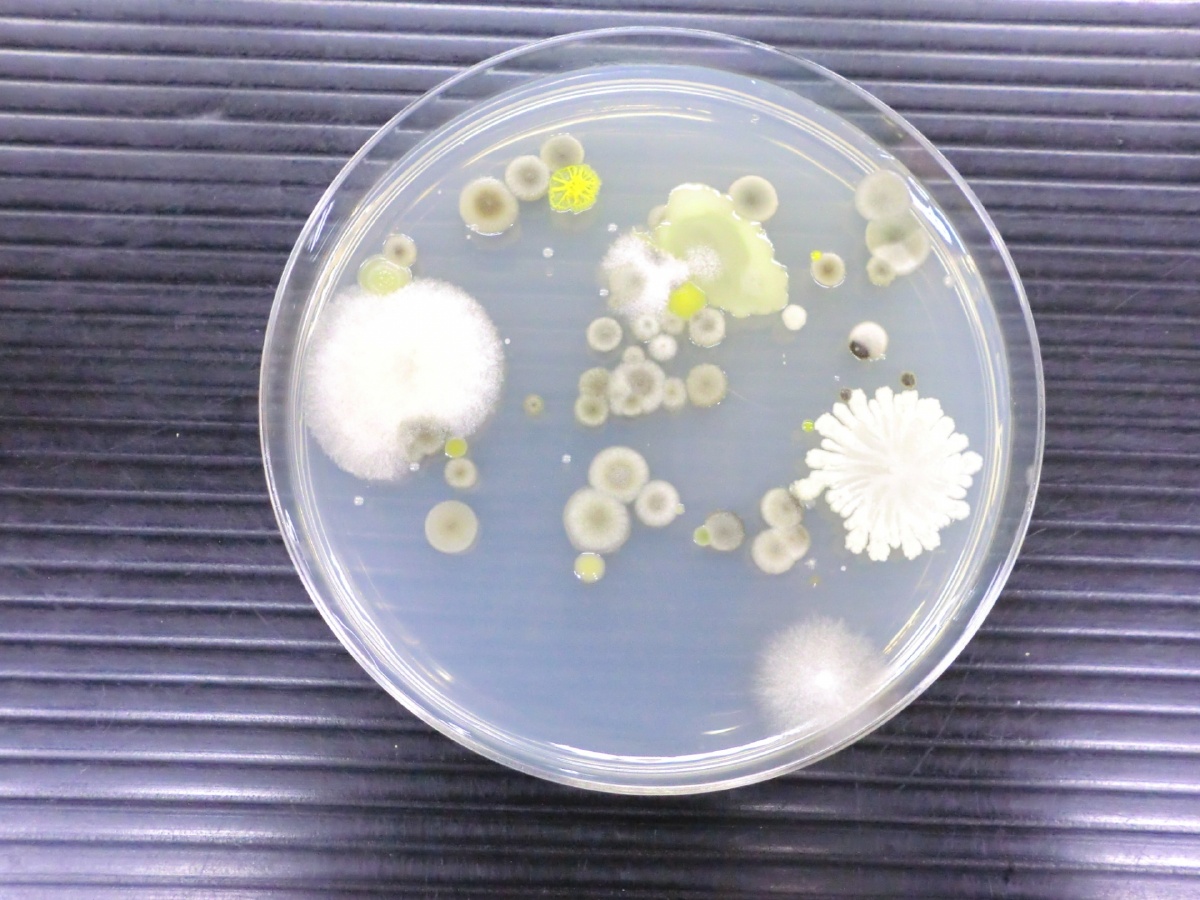
image

インキュベーター・ワークステーション除染システム
MycoFog™ マイコフォグ
MycoFog™ マイコフォグ
 インキュベーターのコンタミ対策に
インキュベーターのコンタミ対策にMycoFog™マイコフォグは過酸化水素(H2O2)のフォグを用いて、インキュベーター、ワークステーションなどの密閉空間から微生物汚染を除去する除染システムです。
簡単なステップで迅速・効果的に除染を行います。
細胞培養または微生物学的インキュベーターを使用するすべてのラボにおすすめです。
MycoFogの特長
手軽に隅々まで除染
試薬を注ぎ、インキュベーター内にMycoFogをセットし、スタートボタンを押すだけ。
過酸化水素フォグがインキュベーター内の凹凸部・ファンなど隅々まで除染します。
迅速に除染完了
わずか180分でインキュベーター内を効果的に除染します。除染後、ラボ機器に残留物を残しません。
※プロトコルにより時間は前後します。
小型・軽量設計で場所を選びません
バッテリー搭載のコードレスタイプのため、さまざまなインキュベーターで使用できます。
ほぼ手のひらサイズでありながら、最大1,200Lのインキュベーターをパワフルに除染します。
試薬を注ぎ、インキュベーター内にMycoFogをセットし、スタートボタンを押すだけ。
過酸化水素フォグがインキュベーター内の凹凸部・ファンなど隅々まで除染します。
迅速に除染完了
わずか180分でインキュベーター内を効果的に除染します。除染後、ラボ機器に残留物を残しません。
※プロトコルにより時間は前後します。
小型・軽量設計で場所を選びません
バッテリー搭載のコードレスタイプのため、さまざまなインキュベーターで使用できます。
ほぼ手のひらサイズでありながら、最大1,200Lのインキュベーターをパワフルに除染します。
インキュベーターのコンタミ対策
インキュベーターはなぜコンタミが起こりやすいのか?
インキュベーターはなぜコンタミが起こりやすいのか?インキュベーターは、温度・湿度・CO₂濃度が安定した培養に最適な環境を作り出す装置です。しかしこの環境は、培養細胞だけでなく、細菌やカビなどの微生物にとっても増殖しやすい条件となります。
特に問題となりやすいのが、
・水皿や結露部に残る水分
・棚板裏やドアパッキンなど清掃が行き届きにくい箇所
・扉開閉時に持ち込まれる外気や作業者由来の微生物
といった目に見えない汚染源です。
一度侵入した微生物は、インキュベーター内で急速に増殖し、コンタミネーションとして顕在化します。
多くの場合、インキュベーター自体が汚染を生み出しているのではなく、持ち込まれた微量の汚染を増幅しているにすぎません。そのため、日常清掃だけでは除去しきれない内部汚染が蓄積すると、コンタミが繰り返し発生する原因となります。
こうしたリスクを根本から低減するには、定期的な除染によって装置内部をリセットし、常にクリーンな培養環境を維持することが重要です。
使用方法

ユーザーズボイス
 "So far, I have had a chance to use it (MycoFog) twice on our incubators.
"So far, I have had a chance to use it (MycoFog) twice on our incubators.We tested after the first biodecontamination cycle using settle plates and found no contamination where we were observing consistent contamination previously.
Similar testing on a second incubator yielded similar results.
The system is very easy to use, instructions and fine.
I like your product."
Donald Pijak,
Manager, Research Facility Operations
University of Pennsylvania
「これまでに2回ほどインキュベーターにMycoFogを使用しました。
以前は常に汚染が確認されていた箇所でも、除染後、モニタリング用プレートを用いた検査で一切の汚染が見られませんでした。
2台目のインキュベーターでも同様の検査を行ったところ、同様の結果が得られました。
システムの操作は非常に簡単で、手順も分かりやすく、とても扱いやすい製品だと思います。大変満足しています」
ドナルド・ピジャック
研究施設運営マネージャー
ペンシルバニア大学


"We were looking for new ways to decontamination our incubators and hypoxic workstation.
The MycoFog proved to be an effective means of keeping the interiors sterile and free of contaminants.
The decontamination cycle takes only 180 minites and leaves no H2O2 residue after the procedure.
The MycoFog is light weight and easy to set up, generating a fog that reaches all surfaces inside the incubator, and is proving to be an extremely valuable addition to our contamination control practices."
Professor William Willmore,
Carleton University, Ottawa, Canada
「インキュベーターや低酸素ワークステーションの新たな除染方法を探していました。
MycoFogは内部を無菌かつコンタミネーションのない状態に保つ有効な手段であることがわかりました。
除染サイクルはわずか180分で完了し、処理後に過酸化水素(H₂O₂)の残留もありません。
MycoFogは軽量で設置も簡単、インキュベーター内部のあらゆる面に届く霧を生成し、当施設のコンタミネーションコントロールにおける非常に有用なツールとなっています。」
ウィリアム・ウィルモア教授
カールトン大学(オタワ、カナダ)


"We have now used the MycoFog system in two of our eight incubators and have thus far found it to be very easy to figure out and implement.
In both instances, adhering to the biological indicator test guidelines, we've observed consistent results aligning with our expectations.
We have had persistent contaminations in the past for these two incubators. There has been no contamination observed in either incubator since first using the system 7 weeks ago.
Overall, it is a good system that is easy enough to integrate into lab protocols and workflows!"
Deborah Schwarz,
CEO Advanced Cellular Dymamics Seattle, WA,US
「現在、8台あるインキュベーターのうち2台でMycoFogシステムを使用していますが、非常にわかりやすく、導入も容易であると感じています。
バイオロジカルインジケーター(BI)試験のガイドラインに従って検証を行ったところ、期待通りの安定した結果が得られました。
これら2台のインキュベーターでは以前から継続的なコンタミネーションに悩まされていましたが、7週間前にMycoFogを導入して以降、いずれの機器でも汚染は確認されていません。
全体として、ラボのプロトコルやワークフローにも容易に組み込める、優れたシステムだと思います。」
デボラ・シュワルツ
CEO 最高経営責任者
アドバンスト・セルラー・ダイマティクス(米国ワシントン州シアトル)
製品仕様

| 商品名 | MycoFog 本体 | |
|---|---|---|
| 品番 | MF-200-500 | MF-500-1200 |
| 対応インキュベーター容量 | 500L未満 | 500L以上1200L未満 |
| 内訳 | 本体、USBケーブル、ウィック | |
| 本体寸法 | 130 x 130 x 105 (mm) | |
| 重量 | 400g | |
| 稼働/充電時間 | 1回/充電時間:8時間 (リチウムイオンバッテリー内蔵) |
|
| 商品名 | MycoFog用試薬 IB<200 |
MycoFog用試薬 IB200-350 |
MycoFog用試薬 IB350-500 |
|---|---|---|---|
| 品番 | MF-FR-Bx200 | MF-FR-Bx350 | MF-FR-Bx500 |
| 対応インキュベーター容量 | 200L未満 | 200L以上350L未満 | 350L以上500L未満 |
| 内訳 | 21mL × 4本 | 28mL × 4本 | 48mL × 2本 |
| 商品名 | MycoFog用試薬 IB500-700 |
MycoFog用試薬 IB700-1000 |
MycoFog用試薬 IB1000-1200 |
| 品番 | MF-FR-Bx700 | MF-FR-Bx1000 | MF-FR-Bx1200 |
| 対応インキュベーター容量 | 500L以上700L未満 | 700L以上1000L未満 | 1000L以上1200L未満 |
| 内訳 | 68mL × 2本 | 95mL × 2本 | 120mL × 2本 |
| 含有成分 | 過酸化水素 7.8% [劇物] | ||
【ご注意】本製品には劇物に該当する成分が含まれています。
ご使用の際は、必ず取扱説明書および安全データシート(SDS)をよくお読みいただき、適切に管理・使用してください。
ご使用の際は、必ず取扱説明書および安全データシート(SDS)をよくお読みいただき、適切に管理・使用してください。
| 商品名 | バイオロジカルインジケーター |
|---|---|
| 品番 | MF-BI |
| 内訳 | 10本入り (Geobacillus stearothermophilus) |
| 商品名 | ファン |
|---|---|
| 品番 | MF-FAN |
カタログダウンロード
カタログはこちらからダウンロードいただけます(PDF)⇒
お問い合わせ
フォームが表示されるまでしばらくお待ち下さい。
恐れ入りますが、しばらくお待ちいただいてもフォームが表示されない場合は、こちらまでお問い合わせください。









